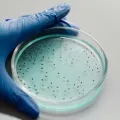
Foto: Divulgação

Utilizamos cookies para personalizar anúncios e melhorar a sua experiência no site. Ao continuar navegando, você concorda com a nossa Política de Privacidade.
Anticoncepcional masculino injetável pode chegar ao mercado até 2028
Método sem hormônios bloqueia espermatozoides e promete efeito reversível por até dois anos.
Um novo método contraceptivo masculino, ainda em fase de testes, pode ampliar as opções de planejamento familiar nos próximos anos. O Adam, desenvolvido pela empresa Contraline, é uma injeção de longa duração que não utiliza hormônios e tem efeito reversível.
A tecnologia consiste na aplicação de um hidrogel diretamente nos canais deferentes, criando uma barreira física que impede a passagem dos espermatozoides. O procedimento é realizado em consultório, com anestesia local, e dura entre 10 e 30 minutos.
Diferente da vasectomia, o método não é permanente. O material aplicado se degrada naturalmente ao longo do tempo, permitindo a retomada da fertilidade. Resultados iniciais indicam que o efeito pode durar até dois anos, período em que foi observada a ausência de espermatozoides no sêmen dos participantes.
Segundo os desenvolvedores, o anticoncepcional ainda depende de novas fases de testes e aprovações, mas a expectativa é de que possa chegar ao mercado até o fim de 2028.
Além disso, outras pesquisas também avançam na área, como uma pílula masculina experimental que atua na produção de espermatozoides e estudos científicos que buscam interferir diretamente no funcionamento das células reprodutivas.
Especialistas apontam que os avanços podem trazer alternativas mais equilibradas na responsabilidade entre homens e mulheres.
MAIS NOTÍCIAS
Café Empresarial da Acislo recebe Alvair Scariot e valoriza trajetória de 58 anos da Tipografia Cruzeiro
Homem é preso dentro da casa da vítima após descumprir medida protetiva em São Lourenço do Oeste
Projeto da Escola São Lourenço une tecnologia, capacitação e geração de renda
Homem é preso por furto e corrupção de menores em São Lourenço do Oeste
NOTÍCIAS RELACIONADAS
Homem é preso dentro da casa da vítima após descumprir medida protetiva em São Lourenço do Oeste
Suspeito de 23 anos havia deixado recentemente a prisão e foi localizado no imóvel no bairro Santa Catarina.
Mulher é presa após agredir e ameaçar filha adolescente em São Lourenço do Oeste
Vítima de 16 anos havia procurado a Polícia Civil para relatar ameaças e solicitar medidas protetivas contra a mãe.
Polícia Civil prende casal com drogas após perseguição e queda de veículo na PRC-158
Motorista teria acelerado contra a equipe policial e continuado a fuga mesmo depois de ter os pneus atingidos.
Homem é preso por furto e corrupção de menores em São Lourenço do Oeste
Oito barras de chocolate foram recuperadas durante uma abordagem no Centro; dois adolescentes também foram apreendidos.
Polícia Civil cumpre prisão preventiva em investigação de feminicídio no Oeste de SC
Crime ocorreu na madrugada de sábado, 13, nas proximidades do cemitério da Aldeia Paiol de Barro; vítima tinha 25 anos e foi morta por ferimentos provocados por arma branca.
Motorista morre após caminhão carregado com placas solares tombar em Seara
Veículo saiu da pista, atingiu postes da rede elétrica e tombou às margens do Contorno Viário; vítima ficou presa às ferragens.